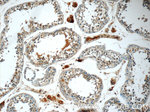
BAALC Antibody in Immunohistochemistry (Paraffin) (IHC (P))

Search
Proteintech
BAALC Polyclonal Antibody
{{$productOrderCtrl.translations['antibody.pdp.commerceCard.promotion.promotions']}}
{{$productOrderCtrl.translations['antibody.pdp.commerceCard.promotion.viewpromo']}}
{{$productOrderCtrl.translations['antibody.pdp.commerceCard.promotion.promocode']}}: {{promo.promoCode}} {{promo.promoTitle}} {{promo.promoDescription}}. {{$productOrderCtrl.translations['antibody.pdp.commerceCard.promotion.learnmore']}}
产品信息
24997-1-AP
种属反应
宿主/亚型
分类
类型
抗原
偶联物
形式
浓度
规格
纯化类型
保存液
内含物
保存条件
运输条件
产品详细信息
Immunogen sequence: MGCGGSRAD AIEPRYYESW TRETESTWLT YTDSDAPPSA AAPDSGPEAG GLHSGMLEDG LPSNGVPRST APGGIPNPEK KTNCETQCPN PQSLSSGPLT QKQNGLQTTE AKRDAKRMPA KEVTINVTDS IQQMDRSRRI TKNCVN (1-145 aa encoded by B C011517)
靶标信息
This gene was identified by gene expression studies in patients with acute myeloid leukemia. The gene is conserved among mammals and is not found in lower organisms. Tissues that express this gene develop from the neuroectoderm. Multiple alternatively spliced transcript variants that encode different proteins have been described for this gene; however, some of the transcript variants are found only in AML cell lines.
仅用于科研。不用于诊断过程。未经明确授权不得转售。
生物信息学
蛋白别名: BAALC, MAP3K1 and KLF4 binding; BAALC, MEKK1 and KLF4 binding; Brain and acute leukemia cytoplasmic protein; brain and acute leukemia, cytoplasmic; FLJ12015; HGNC:14333; unnamed protein product
基因别名: 2810457D07Rik; BAALC
UniProt ID: (Human) Q8WXS3, (Mouse) Q8VHV1
Entrez Gene ID: (Human) 79870, (Mouse) 118452